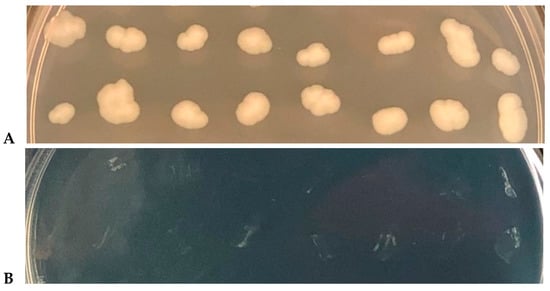

Abstract
Due to their reduced metabolism, persister cells can survive most antimicrobial treatments, which usually rely on corrupting active biochemical pathways. Therefore, molecules that kill bacterial persisters should function in a metabolism-independent manner. Some anti-persister compounds have been found previously, such as the DNA-crosslinkers mitomycin C and cisplatin, but more effective and lower cost alternatives are needed. Copper alloys have been used since ancient times due to their antimicrobial properties, and they are still used in agriculture to control plant bacterial diseases. By stopping transcription with rifampicin and by treating with ampicillin to remove non-persister cells, we created a population that consists solely of Escherichia coli persister cells. Using this population of persister cells, we demonstrate that cupric compounds kill E. coli persister cells. Hence, copper ions may be used in controlling the spread of important bacterial strains that withstand treatment with conventional antimicrobials by forming persister cells.
1. Introduction
Persister cells are a subpopulation of phenotypic variants that are tolerant to antimicrobial compounds. This phenotype was discovered in the early 1940s [1] and occurs primarily as a stress response [2,3,4]. Since they are metabolically inactive [5,6], antibiotics often do not eradicate these cells. The recurrence of microbial diseases has been attributed to persisters, so they constitute a reservoir of cells [7]. Notably, we found that for pathogenic and non-pathogenic E. coli, the viable but non-culturable state and persistence are equivalent [5].
Despite being refractory to many antimicrobial molecules, persister cells can be killed [8,9] by compounds such as cisplatin [10] and mitomycin C [11] that are FDA-approved for cancer treatments, and they can kill persister cells by crosslinking their genomic DNA while they “sleep”. These findings highlight new uses for well-known drugs. In addition, by screening compounds for activity directly on persister cells, the indigoid 5-nitro-3-phenyl-1H-indol-2-yl-methylamine hydrochloride was discovered that kills E. coli, Pseudomonas aeruginosa, and Staphylococcus aureus persister cells [12]. Additionally, retinoids have been found to kill S. aureus persisters [13], and other molecules have been identified [9], although they are not approved yet for persister treatment.
Copper compounds have been used for their antimicrobial properties since ancient times [14], and many different microorganisms are rapidly killed by copper ions [15,16]. Recently, copper alloys have been approved for use by the U.S. Environmental Protection Agency (Reg 82012-1 [17]), due to their effective antimicrobial properties, on important bacteria such as methicillin-resistant S. aureus (MRSA) [18,19], Salmonella enterica [20], and E. coli O157 [21], as well as on bacteriophages [22,23] and Norovirus [24]. Copper is used not only for medical applications but is also used for surfaces [16], since it can prevent the spread of pathogens more effectively than stainless steel alone [18] or silver [19].
The antimicrobial mechanisms of copper ions include membrane damage, oxidative stress, and protein/DNA denaturation [25,26,27]. Critically, these are mainly metabolism-independent mechanisms; hence, we hypothesized that copper can kill persister cells. Although copper has already been linked to the induction of persister cells [28,29,30], here, we demonstrate that copper can also effectively kill E. coli persister cells.
2. Methods
2.1. Bacterial Strains, Growth Media and Chemicals
E. coli BW25113 was used throughout [31] and was grown at 37 °C, with agitation (250 rpm), in lysogeny both [32]. Cisplatin (cis-diamminodichloroplatinum (II)) stocks (1 mg/mL) were diluted in 0.1 M sodium perchlorate [33], since DMSO inactivates cisplatin [34]. Cupric sulfate stocks (0.5 M) were prepared in water. Both solutions were filter-sterilized.
To determine copper minimum inhibitory concentration (MIC), 10 µL of culture (turbidity at 600 nm of ~1.0) was inoculated into lysogeny broth (LB) medium supplemented with a range of copper concentrations: 0, 120, 240, 480, 960, and 1920 µg/mL. Test tubes (final volume 2 mL) were incubated overnight (approximately 16 h with agitation at 250 rpm), and the MIC was determined as the lowest concentration that prevented bacterial growth by visual inspection. All experiments were conducted with at least two biological replicates.
2.2. Persister Cells
Using our previous method [4,5], the persister cell fraction in an E. coli culture was increased 10,000-fold, using a rifampicin pre-treatment to induce cells to enter the persister state. To form these persisters, exponentially growing cells at a turbidity of 0.8 at 600 nm were treated with rifampicin for 30 min at 100 µg/mL, harvested by centrifuging at 1600× g, and resuspended in ampicillin-supplemented LB (100 µg/mL) to kill non-persister cells for 3 h. Then, the cells were centrifuged and resuspended in LB or NaCl buffer.
2.3. ASKA Library Screening for Copper-Resistant Mutants
E. coli electro-competent cells (50 µL) were electroporated with 1 µL of pooled plasmids from a complete set of E. coli K-12 ORF archive (ASKA) (200 ohms, 25 µF, 1.5 kV) using a 0.1 cm electroporation cuvette. LB medium (900 µL) was added and after 1 h of growth (250 rpm), 990 µL of bacterial suspension was inoculated into 25 mL of LB (no antibiotics added), and cells were grown to a turbidity of approximately 0.5 at 600 nm (250 rpm). Chloramphenicol was added (30 µg/mL), and the cells grown for 1 h. After that, 25 µL of this culture were re-inoculated in LB medium supplemented with cupric sulfate (1 × MIC, 960 µg/mL), with or without IPTG (0.5 mM), and grown overnight (250 rpm).
2.4. KEIO Library Screening for Copper-Resistant Mutants
We used two different approaches to identify copper-resistant strains: LB supplemented with cupric sulfate (1 × MIC, 960 µg/mL) and cupric sulfate in NaCl 0.85% buffer. For both methods, 250 µL of the pooled KEIO mutant library was inoculated into 25 mL of LB and grown to a turbidity of approximately 0.8 (250 rpm) to let the cells revive. Cells (25 µL) were added to LB supplemented with cupric sulfate (960 µg/mL, 1 × MIC in LB), and kept overnight (250 rpm) or 5 mL of the revived cells were centrifuged and washed once in 0.85% NaCl buffer and cupric sulfate at approximately 1/6 × MIC (160 µg/mL, from 1 × MIC in LB of 960 µg/mL). This bacterial suspension was incubated for 2 h without shaking at 30 °C.
2.5. Copper Killing Assays
For cells in LB, E. coli exponential and persister cultures (5 mL) were centrifuged, resuspended in 5 mL containing 1 × MIC of cupric sulfate (960 µg/mL), and shaken in 125 mL Erlenmeyer flasks; then, the aliquots were used for serial dilutions. Colony-forming units (CFU) were determined after 3 h and 18 h. For cells in NaCl buffer, the cultures were centrifuged, washed 2 × in NaCl 0.85%, and resuspended in this same buffer. To each 2 mL of this bacterial suspension, cupric sulfate was added (32 µg/mL and 160 µg/mL: final concentrations), and cells were incubated without shaking at 30 °C for 1 h.
2.6. Effect of Oxygen on Copper Activity
Cells were grown to a turbidity of approximately 0.8 and resuspended in 0.85% NaCl with cupric sulfate (160 µg/mL). Cultures were incubated without shaking at 30 °C for 1 h in opened vials (aerobic) and in an anaerobic chamber (Coy Laboratories). Aliquots were serially diluted and plated on LB–agar plates, which were incubated under aerobic and anaerobic conditions.
2.7. Membrane Integrity Assessment by Live/Dead Microscopy
To determine whether copper ions damage the persister cell membrane, we performed a Live/Dead assay. Persister cells (5 mL) were resuspended in 0.85% NaCl supplemented with cupric sulfate (160 µg/mL final). The bacterial suspensions were incubated for 30 and 60 min at 30 °C incubator, without shaking, and washed twice in PBS buffer before the addition of propidium iodide (PI) (Invitrogen P3566) and SYTO 9 (Invitrogen, L7012), reaching final concentrations of 60 µM and 20 µM, respectively. After a 15 min-incubation (room temperature, light-protected), cells were observed under a Zeiss fluorescence microscope (approximate excitation/emission for PI is 490/635 nm, and for SYTO9, it is 485/500 nm). Pictures taken with different filters were merged using ZEN software. As a control, heat-treated E. coli cells were used to confirm the PI staining of dead cells.
2.8. Membrane Integrity Assessment by Lysis Assays
To determine if copper ions cause cell lysis, cells were grown to a turbidity of 0.8, washed twice using NaCl 0.85% (3500× g for 10 min), and the pellet was resuspended in PBS buffer. For the 100% lysed positive control, a 1 mL aliquot was sonicated (20 s, 3 W, 3 cycles, Sonic Dismembrator 60), centrifuged, and the supernatant used as a positive control (which we call “sonicated”). For the copper-treated cultures (5 mL), cupric sulfate was added (160 µg/mL) and vials were incubated for 1 h at 30 °C; then, they were centrifuged (6500× g, 4 °C, 15 min) and the supernatants were collected. Protein detection was determined using BCA protein assay kit (Pierce, Prod#23227), following the manufacturer’s instructions.
2.9. Copper Versus Cisplatin for Killing Persisters
Persister cells were resuspended in LB supplemented with cupric sulfate (1920 µg/mL, 2 × MIC), cisplatin (200 µg/mL, 2 × MIC), or the solvent control for cisplatin, sodium perchlorate (0.1 M), and incubated at 250 rpm. Aliquots for CFU assessment were obtained by serial dilution and colony counting at 0 min, 15 min, 30 min, and 60 min.
2.10. Statistical Analysis
All experiments were carried out with at least two biological replicates. Median values were obtained for each time-point assessed, and the standard deviation was calculated. For statistical significance analysis, we used a t-test (bicaudal, type 1) versus the control conditions and considered a minimum of 0.05 (*) for the p-values.
3. Results
3.1. Copper-Related Proteins in E. coli K-12
Gram-negative strains utilize the cue system (Cu efflux) [35] and the cus system (Cu sensing) [36] for copper detoxification. These systems are chromosomally encoded and are complimentary in function. CopA (cue system) is involved in cytoplasm detoxification, while the cus system is involved in periplasm detoxification [35,37]. Under anaerobiosis, CueO (periplasmic copper detoxification) has its activity impaired, but cus system proteins remain functional, removing copper ions from the periplasm [35,37] (Table 1). Under strong selective pressure (i.e., in copper-rich environments), bacteria may also harbor additional plasmid-borne genetic elements that improve copper tolerance (usually pco genes) and enhance the ability of the bacterium to efflux copper ions [35]. Our reference strain, E. coli BW25113, contains the expected main systems for copper regulation (cus and cue) and is devoid of the plasmid-encoded pco system (Table 1). Therefore, it is a suitable model for copper persistence for E. coli and other Gram-negative bacteria.

Table 1.
Gram-negative copper homeostasis/resistance systems (Bondarczuk and Piotrowska-Seget, 2013) identified in E. coli BW25113.
3.2. Cooper Kills Both Exponential and Persister E. coli Cells
The MIC of copper for E. coli exponential cells was determined to be 960 µg/mL in lysogeny broth (LB) after overnight incubation. Persister cells were formed so that they were the dominant population following the previously published methodology [4,5] that increases persister cells by 10,000-fold; this method uses a rifampicin pre-treatment for 30 min to suppress protein synthesis, and a subsequent ampicillin treatment for 3 h to kill non-persister cells. Our method of generating persister cells has been validated eight ways [38] and utilized by 11 independent labs to date [4,39,40,41,42,43,44,45,46,47,48].
Using the MIC for exponentially growing cells, we investigated the ability of copper ions to kill both exponential and persister cells in rich medium (LB) with 1 × MIC cupric sulfate (960 µg/mL). After 18 h of incubation, the number of viable exponentially grown cells was reduced 1000-fold more than the persister cells (Figure 1A); hence, the exponentially grown cells were more susceptible to copper killing. However, the number of viable cells in both populations continually decreased without a plateau, indicating that copper continues to kill both kinds of cells, although it kills the persister cells less rapidly.

Figure 1.
Exponential and persister cell viability with copper in rich medium and in buffer. (A) Both exponential and persister cells were incubated for 18 h with copper (960 µg/mL cupric sulfate, 1 × minimum inhibitory concentration (MIC)) in lysogeny broth (LB). Error bars indicate standard deviation. (B) Survival under copper stress in 0.85% NaCl buffer after 1 h. Since we could not recover viable cells after incubating with 1 × MIC (160 µg/mL), a 1/5 concentration was used in buffer (32 µg/mL). Relative survival obtained after copper was added to the bacterial suspension in NaCl buffer. The symbols *** (p < 0.001) and ** (p < 0.05) indicate significant differences. NS indicates that non-significant difference was found.
Rich medium is not representative of the conditions bacteria face in natural environments, which are predominantly oligotrophic [49]. In addition, copper ions could be complexed by proteins and/or other molecules present in rich media, which could give us less accurate results [50]. In order to evaluate the effect of copper without these artifacts, both persister and exponential cell cultures were washed with 0.85% NaCl buffer before being challenged with cupric sulfate in NaCl buffer. Our first attempts using the LB-obtained MIC of 960 µg/mL resulted in complete cell death, even after short incubation periods of less than one hour (data not shown). Using a lower concentration (32 µg/mL cupric sulfate) and 1 h of incubation, a significant reduction was found in the number of viable exponential cells, in comparison to cells without cupric sulfate, whereas there was no effect on the persister cells (Figure 1B). At higher concentrations (160 µg/mL cupric sulfate), both exponential and persister cells were eradicated (Figure 1B). These results not only corroborate that exponential cells are killed faster than persisters (as shown previously in LB, Figure 1A), but they also show that persisters can be completely eliminated by cupric sulfate.
3.3. Copper Ions Damage the E. coli Persister Cell Membrane
Since different mechanisms for copper killing have been suggested [27], including cell lysis [51], we investigated whether cell lysis was occurring with E. coli by assessing its membrane status after cupric sulfate treatment via Live/Dead staining. Live/Dead staining uses the membrane-impermeant DNA intercalator propidium iodide and the membrane-permeant DNA intercalator SYTO9 to determine the extent of cell envelope disruption; i.e., cells with membrane damage are stained red, and all cells are stained green by SYTO9.
The microscopy results show that after 160 µg/mL of cupric sulfate in NaCl buffer for 1 h, 58% ± 8% of persister cells have damaged membranes (Figure 2A). The remaining green-stained cells for the copper-treated cultures are also dead, since no surviving cells were recovered with these conditions (Figure 1B). Therefore, membrane damage occurs to a significant extent due to the copper treatment of persister cells, and copper ions might also impair some internal biochemical pathways, leading to cell death.

Figure 2.
Membrane integrity and cell lysis of persister cells with copper. (A) Persister cells were suspended in 0.85% NaCl buffer supplemented with cupric sulfate (160 µg/mL) for 1 h, then treated with Live/Dead staining. Scale bar is 10 µM. (B) Persister cells were treated with copper (160 µg/mL) or 1 × PBS buffer (“no copper”) and protein content was quantified and compared to the positive control of completely-lysed cells via sonication (“sonicated”) * (p < 0.05); ** (p < 0.01).
In addition, we hypothesized that if membrane damage was the leading cause of death by copper ions, we would be able to detect an increase in protein content outside of cells. Therefore, supernatants of the suspensions of persister cells after copper treatment (160 µg/mL of cupric sulfate in NaCl buffer for 1 h) were analyzed, and we found no additional extracellular protein after copper treatment (Figure 2B); hence, we did not find evidence of cell lysis, only evidence of membrane damage.
3.4. Copper Ions Kill More Effectively Anaerobically
Since copper ions has been reported to kill E. coli cells more effectively under anaerobic conditions [51,52], we tested the effect of oxygen on cupric sulfate at 32 µg/mL in NaCl for 1 h for exponentially grown cells. As expected, we found a greater killing of exponential cells in the absence of oxygen (91% ± 2% versus 64% ± 6%, Figure 3).

Figure 3.
Exponentially growing cells with copper under aerobic and anaerobic conditions. Bacterial suspensions in 0.85% NaCl buffer supplemented or not with 32 mg/mL cupric sulfate for 60 min at 30 °C. A “no copper” control was used for each condition for comparison; i.e., for both anaerobic and aerobic conditions and is listed as 100%. The symbol * (p < 0.05) indicates the significant difference compared to the control (“no copper”).
3.5. Absence of Copper Resistance Mutants
Realizing genetic resistance could limit the use of copper as an effective antimicrobial, we assessed the likelihood of copper resistance using pooled libraries [12] of the 3985 KEIO E. coli single-gene knockouts which contains all non-lethal mutations of E. coli K-12 [31] as well as pooled libraries [2] of the ASKA plasmid library [53] where all of the 4287 E. coli proteins are produced. We reasoned that either a deletion or production of a key protein would allow higher copper tolerance and that this approach could also give us additional clues about the mode of action of copper.
For the pooled ASKA strains, after transformation, cells were grown overnight in LB supplemented with 1 × MIC of cupric sulfate (960 µg/mL), with and without 0.5 mM IPTG to induce gene expression. However, no strain capable of growing at 1 × MIC was recovered. For the pooled Keio strains, since 160 µg/mL of cupric sulfate reduces a 108 cell/mL bacterial suspension to zero in 1 h in NaCl buffer (Figure 1B), we exposed the pooled library for 2 h at this condition. Some colonies were recovered using this method, but further testing showed that despite being more tolerant to copper ions during the limited-time exposure (2 h), it did not render these cells able to grow at 1 × MIC (960 µg/mL) during an overnight incubation (Figure 4). Hence, no copper-resistant mutants were obtained.
Figure 4.
Copper-tolerant mutant strains are unable to withstand 1 × MIC in rich medium. (A) Copper tolerant mutants obtained after a 2 h exposition to 160 µg/mL cupric sulfate in NaCl buffer grow normally in LB agar plates after an overnight incubation without copper. (B) The same mutants shown in A, but now on a copper-supplemented LB agar plate (1 × MIC, 960 µg/mL). Note that despite being selected for being more tolerant to copper in a short-duration experiment (in NaCl buffer for 2 h), the cells are unable to survive at 1 × MIC when incubated.
3.6. Copper Ions Are More Effective than Cisplatin for Eradicating Persisters
We compared the effectiveness of copper ions to another well-known persister-killing molecule, cisplatin [10], for killing E. coli persisters. After 30 min of incubation with 2 × MIC for each of these chemicals in LB, copper ions eradicated the persister cells faster than cisplatin (Figure 5), demonstrating that copper is more effective than cisplatin for eliminating E. coli persister cells.

Figure 5.
Copper is more effective than cisplatin for killing persister cells. Persister cells were treated with cisplatin (200 µg/mL, 2 × MIC), cupric sulfate (1920 µg/mL, 2 × MIC), or sodium perchlorate (solvent control for cisplatin) for 30 min in LB. Aliquots for CFU assessment were taken at 0, 15, 30, and 60 min. The symbol ** (p < 0.01) indicates the significant difference compared to the control (NaO4Cl), using all the time-points values for each condition as a matrix to compare with all the time points obtained for the control. “ns” indicates that a non-significant difference was found.
4. Discussion
Although copper is an essential element for life [54,55,56], it is toxic [57,58], and many different modes of action have been proposed for this molecule. Besides lipid and DNA oxidation [15], proteins can suffer mismetallation [59], misfolding [60], and the destruction of Fe–S clusters [61] in the presence of copper. Interestingly, the reason for the essentiality and destructive potential of copper is the same: it is highly reactive [54,56]. After the Earth’s atmosphere became oxygenated, the conversion of Cu+1 to Cu+2 increased the availability of this metal availability for biocatalysis [15,62]. As a result, many respiratory-related proteins need this metal to function properly [63], but its homeostasis needs to be strictly controlled by the cell to avoid its lethality [15,64].
Despite a matter of debate, the formation of reactive oxygen species (ROS) was thought to be one of the main reasons for copper ions’ toxicity [53,61]. Indeed, oxidative stress occurs [61], but it might be the result of downstream effects, after the primary targets are attacked by copper ions [35,52,61]. This has been shown by recent studies that indicate that the primary reason for copper toxicity is the destruction of an Fe–S cluster of proteins, which is an oxygen-independent process that is enhanced under anaerobic conditions [52,62,65]. In our study, we also found that under anaerobic conditions, copper ions were more lethal to exponentially grown E. coli cells (Figure 3), and our attempts to reduce ROS from copper by using glutathione were not successful (data not shown).
Other modes of action for copper have also been proposed, including contact killing by cell envelope-associated damage [27,66]. In our study, we found clear evidence of membrane damage (Figure 2A) but not lysis, since no extra cellular protein (Figure 2B) was found. Regardless of its exact killing mechanism, copper ions are potent antimicrobial molecules. In fact, macrophages utilize copper ions to kill microbes [67,68] and copper deficiency in humans and animals is linked to an increase in infection [69].
Unlike many antibiotics, copper resistance is unlikely to occur spontaneously [70], requiring the acquisition of plasmid-based operons to enhance copper homeostasis [71]. This may explain our unsuccessful attempts to recover copper-resistant mutants using both KEIO and ASKA libraries; however, more testing is required using longer times for mutants to occur and strains that are more medically relevant. Genomic analysis performed on E coli BW25113 showed that it has no pco operon, although copper homeostasis genes were fully present. Additionally, many medically relevant E. coli strains are susceptible to copper [21], and even in the presence of supplemental copper-resistance genes, most bacteria die on cupric surfaces, although they may need more contact time for this to happen [72,73,74].
5. Conclusions
Critically, one of the main results of this work is that due to the metabolism-independent membrane damage caused by copper ions, we verified that it is capable of killing E. coli persister cells (Figure 1). Although the medical use of copper requires steps to limit its toxicity, our results suggest new therapeutic alternatives to control persister cells, as well as suggest a continued use of copper surfaces to kill bacteria. For example, copper-coated surfaces in hospitals could decrease the occurrence of healthcare-associated infections, which can reach rates as high as 6% of acute care inpatients [75]. In addition to surfaces, many other uses of copper ions could be envisioned [76], especially because there are other important sources of contamination inoculum in hospitals, besides hand-touched surfaces, such as white coats [76,77,78]. To our knowledge, this is the first study to show that cupric compounds can effectively kill persister cells. Hence, in addition to the long-known antimicrobial properties of copper materials, its use could be expanded to include dormant cells, helping in the ever-increasing need to fight pathogens.
Author Contributions
Investigation, P.M.M.M. and T.G.; Supervision, A.A.d.S. and T.K.W.; Writing—original draft, P.M.M.M.; Writing—review & editing, T.K.W. All authors have read and agreed to the published version of the manuscript.
Funding
Fundação de Amparo à Pesquisa do Estado de São Paulo: 2018/18550-0.
Acknowledgments
P.M.M.M. was a recipient of a research grant FAPESP 2018/18550-0. We would like also to thank the National Institute of Genetics of Japan for providing Keio and ASKA libraries used in this study. T.K.W. was supported by funds derived from the Biotechnology Endowed Professorship at the Pennsylvania State University.
Conflicts of Interest
The authors have no conflicts of interest.
References
- Hobby, G.L.; Meyer, K.; Chaffee, E. Observations on the Mechanism of Action of Penicillin. Exp. Biol. Med. 1942, 50, 281–285. [Google Scholar] [CrossRef]
- Yamasaki, R.; Song, S.; Benedik, M.J.; Wood, T.K. Persister Cells Resuscitate Using Membrane Sensors that Activate Chemotaxis, Lower cAMP Levels, and Revive Ribosomes. iScience 2020, 23, 100792. [Google Scholar] [CrossRef] [PubMed]
- Dörr, T.; Vulić, M.; Lewis, K. Ciprofloxacin causes persister formation by inducing the TisB toxin in Escherichia coli. PLoS Biol. 2010, 8, e1000317. [Google Scholar]
- Kwan, B.W.; Valenta, J.A.; Benedik, M.J.; Wood, T.K. Arrested protein synthesis increases persister-like cell formation. Antimicrob. Agents Chemother. 2013, 57, 1468–1473. [Google Scholar] [CrossRef]
- Kim, J.-S.; Chowdhury, N.; Yamasaki, R.; Wood, T.K. Viable but non-culturable and persistence describe the same bacterial stress state. Environ. Microbiol. 2018, 20, 2038–2048. [Google Scholar] [CrossRef] [PubMed]
- Wood, T.K.; Knabel, S.J.; Kwan, B.W. Bacterial persister cell formation and dormancy. Appl. Environ. Microbiol. 2013, 79, 7116–7121. [Google Scholar] [CrossRef]
- Michiels, J.E.; Van den Bergh, B.; Verstraeten, N.; Michiels, J. Molecular mechanisms and clinical implications of bacterial persistence. Drug Resist. Updat. 2016, 29, 76–89. [Google Scholar] [CrossRef]
- Kim, J.-S.; Wood, T.K. Persistent Persister Misperceptions. Front. Microbiol. 2016, 7, 2134. [Google Scholar] [CrossRef]
- Defraine, V.; Fauvart, M.; Michiels, J. Fighting bacterial persistence: Current and emerging anti-persister strategies and therapeutics. Drug Resist. Updat. 2018, 38, 12–26. [Google Scholar] [CrossRef]
- Chowdhury, N.; Wood, T.L.; Martínez-Vázquez, M.; García-Contreras, R.; Wood, T.K. DNA-crosslinker cisplatin eradicates bacterial persister cells. Biotechnol. Bioeng. 2016, 113, 1984–1992. [Google Scholar] [CrossRef]
- Kwan, B.W.; Chowdhury, N.; Wood, T.K. Combatting bacterial infections by killing persister cells with mitomycin C. Environ. Microbiol. 2015, 17, 4406–4414. [Google Scholar] [CrossRef] [PubMed]
- Song, S.; Gong, T.; Yamasaki, R.; Kim, J.; Wood, T.K. Identification of a potent indigoid persister antimicrobial by screening dormant cells. Biotechnol. Bioeng. 2019, 116, 2263–2274. [Google Scholar] [CrossRef] [PubMed]
- Kim, W.; Zhu, W.; Hendricks, G.L.; Van Tyne, D.; Steele, A.D.; Keohane, C.E.; Fricke, N.; Conery, A.L.; Shen, S.; Pan, W.; et al. A new class of synthetic retinoid antibiotics effective against bacterial persisters. Nature 2018, 556, 103–107. [Google Scholar] [CrossRef]
- Krivoshapkin, A.L.; Chikisheva, T.A.; Zubova, A.V.; Kurbatov, V.P.; Titov, A.T.; Volkov, P.V. Scythian trepanations in the gorny altai in hippocratic times: Modern expert appraisal of ancient surgical technologies. World Neurosurg. 2014, 82, e649–e655. [Google Scholar] [CrossRef] [PubMed]
- Dupont, C.L.; Grass, G.; Rensing, C. Copper toxicity and the origin of bacterial resistance—New insights and applications. Metallomics 2011, 3, 1109–1118. [Google Scholar] [CrossRef]
- Ibrahim, Z.; Petrusan, A.J.; Hooke, P.; Hinsa-Leasure, S.M. Reduction of bacterial burden by copper alloys on high-touch athletic center surfaces. Am. J. Infect. Control 2018, 46, 197–201. [Google Scholar] [CrossRef]
- EPA. Antimicrobial Copper Alloys. 2013. Available online: https://www3.epa.gov/pesticides/chem_search/ppls/085353-00003-20130103.pdf (accessed on 1 May 2019).
- Noyce, J.O.; Michels, H.; Keevil, C.W. Potential use of copper surfaces to reduce survival of epidemic meticillin-resistant Staphylococcus aureus in the healthcare environment. J. Hosp. Infect. 2006, 63, 289–297. [Google Scholar] [CrossRef]
- Michels, H.T.; Noyce, J.O.; Keevil, C.W. Effects of temperature and humidity on the efficacy of methicillin- resistant Staphylococcus aureus challenged antimicrobial materials containing silver and copper. Lett. Appl. Microbiol. 2009, 49, 191–195. [Google Scholar] [CrossRef]
- Zhu, L.; Elguindi, J.; Rensing, C.; Ravishankar, S. Antimicrobial activity of different copper alloy surfaces against copper resistant and sensitive Salmonella enterica. Food Microbiol. 2012, 30, 303–310. [Google Scholar] [CrossRef]
- Noyce, J.O.; Michels, H.; Keevil, C.W. Use of copper cast alloys to control Escherichia coli O157 cross-contamination during food processing. Appl. Environ. Microbiol. 2006, 72, 4239–4244. [Google Scholar] [CrossRef]
- Noyce, J.O.; Michels, H.; Keevil, C.W. Inactivation of influenza A virus on copper versus stainless steel surfaces. Appl. Environ. Microbiol. 2007, 73, 2748–2750. [Google Scholar] [CrossRef] [PubMed]
- Li, J.; Dennehy, J.J. Differential bacteriophage mortality on exposure to copper. Appl. Environ. Microbiol. 2011, 77, 6878–6883. [Google Scholar] [CrossRef] [PubMed]
- Warnes, S.L.; Keevil, C.W. Inactivation of Norovirus on Dry Copper Alloy Surfaces. PLoS ONE 2013, 8, e75017. [Google Scholar] [CrossRef] [PubMed]
- Karlsson, H.L.; Cronholm, P.; Hedberg, Y.; Tornberg, M.; De Battice, L.; Svedhem, S.; Wallinder, I.O. Cell membrane damage and protein interaction induced by copper containing nanoparticles-Importance of the metal release process. Toxicology 2013, 313, 59–69. [Google Scholar] [CrossRef]
- Chaturvedi, K.S.; Henderson, J.P. Pathogenic adaptations to host-derived antibacterial copper. Front. Cell. Infect. Microbiol. 2014, 4, 3. [Google Scholar] [CrossRef] [PubMed]
- Vincent, M.; Duval, R.E.; Hartemann, P.; Engels-Deutsch, M. Contact killing and antimicrobial properties of copper. J. Appl. Microbiol. 2018, 124, 1032–1046. [Google Scholar] [CrossRef] [PubMed]
- Grey, B.; Steck, T.R. Concentrations of copper thought to be toxic to Escherichia coli can induce the viable but nonculturable condition. Appl. Environ. Microbiol. 2001, 67, 5325–5327. [Google Scholar] [CrossRef]
- Bédard, E.; Charron, D.; Lalancette, C.; Déziel, E.; Prévost, M. Recovery of Pseudomonas aeruginosa culturability following copper- and chlorine-induced stress. FEMS Microbiol. Lett. 2014, 356, 226–234. [Google Scholar] [CrossRef]
- Dopp, E.; Richard, J.; Dwidjosiswojo, Z.; Simon, A.; Wingender, J. Influence of the copper-induced viable but non-culturable state on the toxicity of Pseudomonas aeruginosa towards human bronchial epithelial cells in vitro. Int. J. Hyg. Environ. Health 2017, 220, 1363–1369. [Google Scholar] [CrossRef]
- Baba, T.; Ara, T.; Hasegawa, M.; Takai, Y.; Okumura, Y.; Baba, M.; Datsenko, K.A.; Tomita, M.; Wanner, B.L.; Mori, H. Construction of Escherichia coli K-12 in-frame, single-gene knockout mutants: The Keio collection. Mol. Syst. Biol. 2006, 2, 2006.0008. [Google Scholar] [CrossRef]
- Sambrook, J.; Fritsch, E.F.; Maniatis, T. Molecular Cloning, A Laboratory Manual; Cold Spring Harbor Laboratory Press: New York, NY, USA, 1989. [Google Scholar]
- Chválová, K.; Brabec, V.; Kašpárková, J. Mechanism of the formation of DNA-protein cross-links by antitumor cisplatin. Nucleic Acids. Res. 2007, 35, 1812–1821. [Google Scholar] [CrossRef] [PubMed]
- Hall, M.D.; Telma, K.A.; Chang, K.E.; Lee, T.D.; Madigan, J.P.; Lloyd, J.R.; Goldlust, I.S.; Hoeschele, J.D.; Gottesman, M.M. Say no to DMSO: Dimethylsulfoxide inactivates cisplatin, carboplatin, and other platinum complexes. Cancer Res. 2014, 74, 3913–3922. [Google Scholar] [CrossRef] [PubMed]
- Bondarczuk, K.; Piotrowska-Seget, Z. Molecular basis of active copper resistance mechanisms in Gram-negative bacteria. Cell Biol. Toxicol. 2013, 29, 397–405. [Google Scholar] [CrossRef] [PubMed]
- Mealman, T.D.; Blackburn, N.J.; McEvoy, M.M. Metal Export by CusCFBA, the Periplasmic Cu(I)/Ag(I) Transport System of Escherichia coli. Curr. Top. Membr. 2012, 69, 163–196. [Google Scholar] [PubMed]
- Outten, F.W.; Huffman, D.L.; Hale, J.A.; O’Halloran, T.V. The Independent cue and cus Systems Confer Copper Tolerance during Aerobic and Anaerobic Growth in Escherichia coli. J. Biol. Chem. 2001, 276, 30670–30677. [Google Scholar] [CrossRef] [PubMed]
- Kim, J.S.; Yamasaki, R.; Song, S.; Zhang, W.; Wood, T.K. Single cell observations show persister cells wake based on ribosome content. Environ. Microbiol. 2018, 20, 2085–2098. [Google Scholar] [CrossRef] [PubMed]
- Cui, P.; Niu, H.; Shi, W.; Zhang, S.; Zhang, W.; Zhang, Y. Identification of genes involved in bacteriostatic antibiotic-induced persister formation. Front. Microbiol. 2018, 9, 413. [Google Scholar] [CrossRef]
- Sun, F.; Bian, M.; Li, Z.; Lv, B.; Gao, Y.; Wang, Y.; Fu, X. 5-Methylindole Potentiates Aminoglycoside Against Gram-Positive Bacteria Including Staphylococcus aureus Persisters Under Hypoionic Conditions. Front. Cell. Infect. Microbiol. 2020, 10, 84. [Google Scholar] [CrossRef]
- Grassi, L.; Di Luca, M.; Maisetta, G.; Rinaldi, A.C.; Esin, S.; Trampuz, A.; Batoni, G. Generation of persister cells of Pseudomonas aeruginosa and Staphylococcus aureus by chemical treatment and evaluation of their susceptibility to membrane-targeting agents. Front. Microbiol. 2017, 8, 1917. [Google Scholar] [CrossRef]
- Narayanaswamy, V.P.; Keagy, L.L.; Duris, K.; Wiesmann, W.; Loughran, A.J.; Townsend, S.M.; Baker, S. Novel glycopolymer eradicates antibiotic- and CCCP-induced persister cells in Pseudomonas aeruginosa. Front. Microbiol. 2018, 9, 1724. [Google Scholar] [CrossRef]
- Pu, Y.; Li, Y.; Jin, X.; Tian, T.; Ma, Q.; Zhao, Z.; Lin, S.-Y.; Chen, Z.; Li, B.; Yao, G.; et al. ATP-Dependent Dynamic Protein Aggregation Regulates Bacterial Dormancy Depth Critical for Antibiotic Tolerance. Mol. Cell 2019, 73, 143–156. [Google Scholar] [CrossRef] [PubMed]
- Sulaiman, J.E.; Hao, C.; Lam, H. Specific Enrichment and Proteomics Analysis of Escherichia coli Persisters from Rifampin Pretreatment. J. Proteome. Res. 2018, 17, 3984–3996. [Google Scholar] [CrossRef] [PubMed]
- Tkhilaishvili, T.; Lombardi, L.; Klatt, A.B.; Trampuz, A.; Di Luca, M. Bacteriophage Sb-1 enhances antibiotic activity against biofilm, degrades exopolysaccharide matrix and targets persisters of Staphylococcus aureus. Int. J. Antimicrob. Agents 2018, 52, 842–853. [Google Scholar] [CrossRef] [PubMed]
- Rowe, S.E.; Wagner, N.J.; Li, L.; Beam, J.E.; Wilkinson, A.D.; Radlinski, L.C.; Zhang, Q.; Miao, E.A.; Conlon, B.P. Reactive oxygen species induce antibiotic tolerance during systemic Staphylococcus aureus infection. Nat. Microbiol. 2020, 5, 282–290. [Google Scholar] [CrossRef]
- Zhao, Y.; Lv, B.; Sun, F.; Liu, J.; Wang, Y.; Gao, Y.; Qi, F.; Chang, Z.; Fu, X. Rapid freezing enables aminoglycosides to eradicate bacterial persisters via enhancing mechanosensitive channel mscl-mediated antibiotic uptake. MBio 2020, 11, e03239-19. [Google Scholar] [CrossRef]
- Yu, W.; Li, D.; Li, H.; Tang, Y.; Tang, H.; Ma, X.; Liu, Z. Absence of tmRNA Increases the Persistence to Cefotaxime and the Intercellular Accumulation of Metabolite GlcNAc in Aeromonas veronii. Front. Cell. Infect. Microbiol. 2020, 10, 44. [Google Scholar] [CrossRef]
- Hobbie, J.E.; Hobbie, E.A. Microbes in nature are limited by carbon and energy: The starving-survival lifestyle in soil and consequences for estimating microbial rates. Front. Microbiol. 2013, 4, 324. [Google Scholar] [CrossRef]
- Holm, T.R. Copper complexation by natural organic matter in contaminated and uncontaminated ground water. Chem. Speciat. Bioavailab. 1990, 2, 63–76. [Google Scholar] [CrossRef]
- Hong, R.; Kang, T.Y.; Michels, C.A.; Gadura, N. Membrane lipid peroxidation in copper alloy-mediated contact killing of Escherichia coli. Appl. Environ. Microbiol. 2012, 78, 1776–1784. [Google Scholar] [CrossRef]
- Tan, G.; Yang, J.; Li, T.; Zhao, J.; Sun, S.; Li, X.; Lin, C.; Li, J.; Zhou, H.; Lyu, J.; et al. Anaerobic copper toxicity and iron-sulfur cluster biogenesis in Escherichia coli. Appl. Environ. Microbiol. 2017, 83, e00867-17. [Google Scholar] [CrossRef]
- Kitagawa, M.; Ara, T.; Arifuzzaman, M.; Ioka-Nakamichi, T.; Inamoto, E.; Toyonaga, H.; Mori, H. Complete set of ORF clones of Escherichia coli ASKA library (A complete set of E. coli K-12 ORF archive): Unique resources for biological research. DNA Res. 2005, 12, 291–299. [Google Scholar] [CrossRef] [PubMed]
- Borkow, G.; Gabbay, J. Copper, an Ancient Remedy Returning to Fight Microbial, Fungal and Viral Infections. Curr. Chem. Biol. 2009, 3, 272–278. [Google Scholar]
- Konieczny, J.; Rdzawski, Z. Antibacterial properties of copper and its alloys. Arch. Mater. Sci. Eng. 2012, 56, 53–60. [Google Scholar]
- Thummeepak, R.; Pooalai, R.; Harrison, C.; Gannon, L.; Thanwisai, A.; Chantratita, N.; Millard, A.D.; Sitthisak, S. Essential gene clusters involved in copper tolerance identified in Acinetobacter baumannii clinical and environmental isolates. Pathogens 2020, 9, 60. [Google Scholar] [CrossRef]
- Hordyjewska, A.; Popiołek, Ł.; Kocot, J. The many “faces” of copper in medicine and treatment. Biometals 2014, 27, 611–621. [Google Scholar] [CrossRef]
- Brewer, G.J. The risks of copper toxicity contributing to cognitive decline in the aging population and to alzheimer’s disease. J. Am. Coll. Nutr. 2009, 28, 238–642. [Google Scholar] [CrossRef] [PubMed]
- Johnson, M.D.L.; Kehl-Fie, T.E.; Rosch, J.W. Copper intoxication inhibits aerobic nucleotide synthesis in Streptococcus pneumoniae. Metallomics 2015, 7, 786–794. [Google Scholar] [CrossRef] [PubMed]
- Kershaw, C.J.; Brown, N.L.; Constantinidou, C.; Patel, M.D.; Hobman, J.L. The expression profile of Escherichia coli K-12 in response to minimal, optimal and excess copper concentrations. Microbiology 2005, 151, 1187–1198. [Google Scholar] [CrossRef]
- Macomber, L.; Imlay, J.A. The iron-sulfur clusters of dehydratases are primary intracellular targets of copper toxicity. Proc. Natl. Acad. Sci. USA 2009, 106, 8344–8349. [Google Scholar] [CrossRef] [PubMed]
- Crichton, R.R.; Pierre, J.L. Old iron, young copper: From Mars to Venus. Biometals 2001, 14, 99–112. [Google Scholar] [CrossRef]
- Argüello, J.M.; Raimunda, D.; Padilla-Benavides, T. Mechanisms of copper homeostasis in bacteria. Front. Cell. Infect. Microbiol. 2013, 3, 73. [Google Scholar] [CrossRef] [PubMed]
- Franke, S.; Grass, G.; Rensing, C.; Nies, D.H. Molecular analysis of the copper-transporting efflux system CusCFBA of Escherichia coli. J. Bacteriol. 2003, 185, 3804–3812. [Google Scholar] [CrossRef] [PubMed]
- Djoko, K.Y.; McEwan, A.G. Antimicrobial action of copper is amplified via inhibition of heme biosynthesis. ACS Chem. Biol. 2013, 8, 2217–2223. [Google Scholar] [CrossRef] [PubMed]
- Grass, G.; Rensing, C.; Solioz, M. Metallic copper as an antimicrobial surface. Appl. Environ. Microbiol. 2011, 77, 1541–1577. [Google Scholar] [CrossRef] [PubMed]
- Stafford, S.L.; Bokil, N.J.; Achard, M.E.S.; Kapetanovic, R.; Schembri, M.A.; Mcewan, A.G.; Sweet, M.J. Metal ions in macrophage antimicrobial pathways: Emerging roles for zinc and copper. Biosci. Rep. 2013, 33, 541–554. [Google Scholar] [CrossRef]
- Wagner, D.; Maser, J.; Lai, B.; Cai, Z.; Barry, C.E.; Höner zu Bentrup, K.; Russell, D.G.; Bermudez, L.E. Elemental Analysis of Mycobacterium avium-, Mycobacterium tuberculosis-, and Mycobacterium smegmatis-Containing Phagosomes Indicates Pathogen-Induced Microenvironments within the Host Cell’s Endosomal System. J. Immunol. 2005, 174, 1491–1500. [Google Scholar] [CrossRef]
- Samanovic, M.I.; Ding, C.; Thiele, D.J.; Darwin, K.H. Copper in microbial pathogenesis: Meddling with the metal. Cell Host Microbe 2012, 11, 106–115. [Google Scholar] [CrossRef]
- Behlau, F.; Hong, J.C.; Jones, J.B.; Graham, J.H. Evidence for acquisition of copper resistance genes from different sources in citrus-associated xanthomonads. Phytopathology 2013, 103, 409–418. [Google Scholar] [CrossRef]
- Marin, T.G.S.; Galvanin, A.L.; Lanza, F.E.; Behlau, F. Description of copper tolerant Xanthomonas citri subsp. citri and genotypic comparison with sensitive and resistant strains. Plant Pathol. 2019, 68, 1088–1098. [Google Scholar] [CrossRef]
- Santo, C.E.; Taudte, N.; Nies, D.H.; Grass, G. Contribution of copper ion resistance to survival of Escherichia coli on metallic copper surfaces. Appl. Environ. Microbiol. 2008, 74, 977–986. [Google Scholar] [CrossRef]
- Elguindi, J.; Wagner, J.; Rensing, C. Genes involved in copper resistance influence survival of Pseudomonas aeruginosa on copper surfaces. J. Appl. Microbiol. 2009, 106, 1448–1455. [Google Scholar] [CrossRef] [PubMed]
- Elguindi, J.; Moffitt, S.; Hasman, H.; Andrade, C.; Raghavan, S.; Rensing, C. Metallic copper corrosion rates, moisture content, and growth medium influence survival of copper ion-resistant bacteria. Appl. Microbiol. Biotechnol. 2011, 89, 1963–1970. [Google Scholar] [CrossRef] [PubMed]
- Magill, S.S.; Hellinger, W.; Cohen, J.; Kay, R.; Bailey, C.; Boland, B.; de Guzman, J.; Dominguez, K.; Edwards, J.; Goraczewski, L.; et al. Prevalence of Healthcare-Associated Infections in Acute Care Hospitals in Jacksonville, Florida. Infect. Control Hosp. Epidemiol. 2012, 33, 283–291. [Google Scholar] [CrossRef] [PubMed]
- Borkow, G.; Gabbay, J. Putting copper into action: Copper-impregnated products with potent biocidal activities. FASEB J. 2004, 18, 1728–1730. [Google Scholar] [CrossRef] [PubMed]
- Munoz-Price, L.S.; Arheart, K.L.; Mills, J.P.; Cleary, T.; Depascale, D.; Jimenez, A.; Fajardo-Aquino, Y.; Coro, G.; Birnbach, D.J.; Lubarsky, D.A. Associations between bacterial contamination of health care workers’ hands and contamination of white coats and scrubs. Am. J. Infect. Control 2012, 40, e245–e248. [Google Scholar] [CrossRef] [PubMed]
- Maillard, J.Y.; Hartemann, P. Silver as an antimicrobial: Facts and gaps in knowledge. Crit. Rev. Microbiol. 2013, 39, 373–383. [Google Scholar] [CrossRef]
© 2020 by the authors. Licensee MDPI, Basel, Switzerland. This article is an open access article distributed under the terms and conditions of the Creative Commons Attribution (CC BY) license (http://creativecommons.org/licenses/by/4.0/).